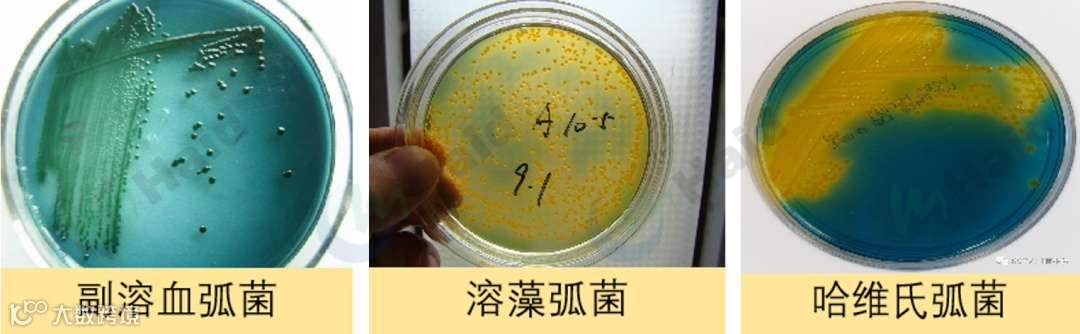
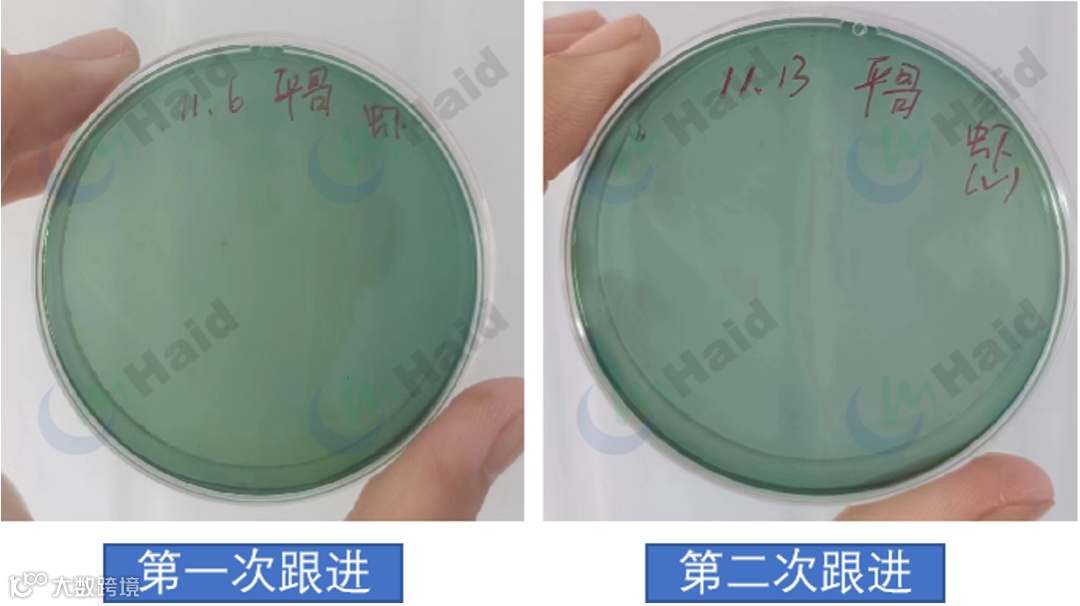
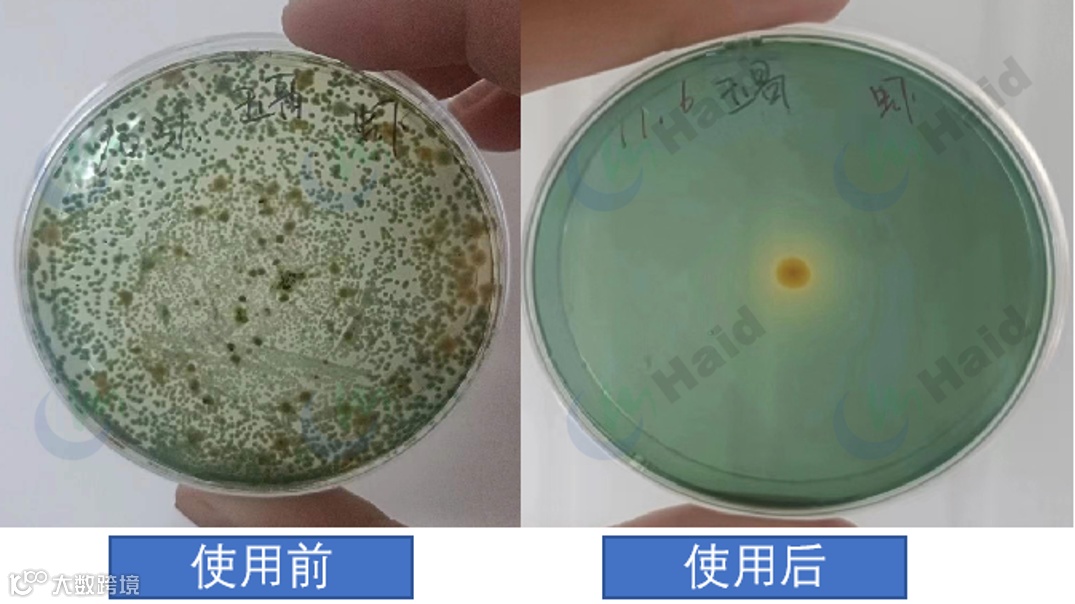
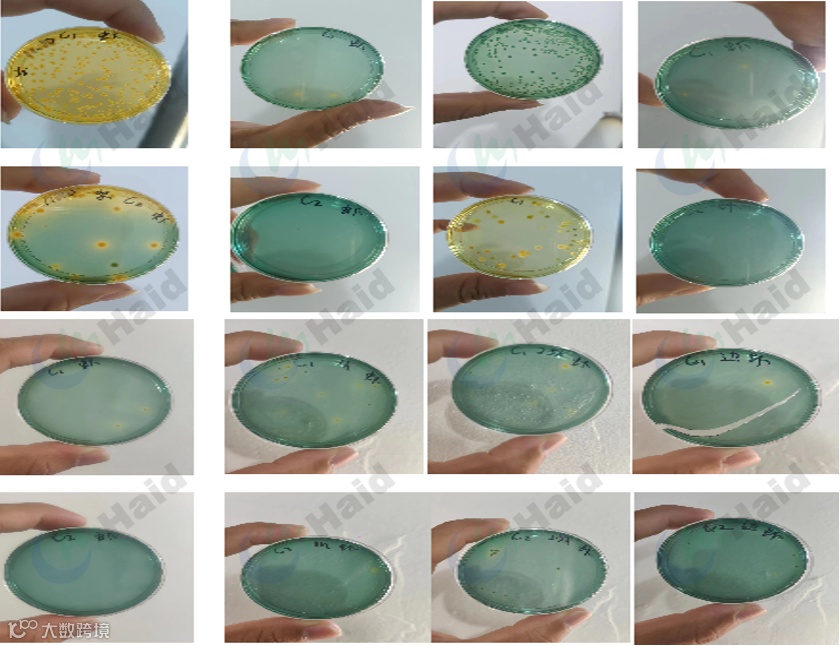

文 | 图
动保事业部 张亚军
湛江海大服务部 韦寿永 孙榕泽
为保障对虾顺利养殖,弧菌防控管理必须要升级强化。
弧菌是指一类菌体短小,弯曲成弧形,尾部带一鞭毛的兼性厌氧菌。其广泛分布于入海口、近岸海域及海洋动物体内,许多种类具有致病性。
弧菌侵袭到对虾体内,其增殖、代谢的过程,会产生大量的有害物质(肠毒素、溶血毒素),降低虾体抵抗力,进一步引起其他病变。
弧菌是目前对虾养殖的头号杀手,危害极大。
△常见弧菌种类
弧菌难防难控,以往大家重点放在处理水体中的弧菌,虽然消毒剂处理水体弧菌效果明显,但无法达到虾体内部,对虾一旦感染弧菌,难以有效处理,造成虾子发病、迫收,甚至排塘,危害严重。
目前,市场上有一些处理体内弧菌的方法,主要是以有益菌抑制、抗生素杀灭为主。其中,抗生素的肆意滥用,对弧菌耐药性影响巨大,导致弧菌危害日益加重,近乎无药可用。可以说,行业对防控弧菌的需求达到顶峰。
面对养殖突出的弧菌问题,海大研究院推出抗弧新品——清弧肽,清弧肽含有抗菌肽和营养物质,拌料内服,抑制体内弧菌。一经上市,便取得了市场认可的好效果,打开了弧菌防控新局面。
1.基本信息
浅黄色粉末物(有微小色差),溶水有少量沉淀物。
芽孢杆菌及其代谢产物抗菌肽、多种维生素、植物精华等。

△清弧肽样品
2.作用机理
抗菌肽成分,破坏细菌细胞膜,抑制弧菌生长。
清除机体自由基,减少组织损伤。

△清弧肽作用机理
效果点1:对黄、绿弧菌有抑制作用
清弧肽上市后,海大工程师团队在湛江养殖核心区域南三岛、乐民镇、企水镇对本地弧菌菌种进行抑菌实验。
结果显示:滴有生理盐水的区域,弧菌正常生长;滴有清弧肽样品的位置没有弧菌生长,清弧肽对湛江区域的黄绿弧菌抑制效果明显。

△清弧肽抑菌实验结果
效果点2:预防使用,使弧菌维持在较低水平
遂溪乐民黄老板10月21日放一塘斑节(60万)标粗,由于乐民区域今年中造斑节弧菌的危害极大,因此黄老板苗期特别关注虾体弧菌,10月底清弧肽刚上市,就同海大的业务员沟通拉货。
11月3日拉到塘头开始使用,每日拌喂一餐,持续使用,拌喂量1%。11月6日和13日跟进两次,取4条虾混检,虾体肝脏都无弧菌,无其他异常情况,养殖特别顺利。
△黄老板处弧菌检测结果,长期使用清弧肽抑制体内弧菌生长
效果点3:治疗使用,降低体内弧菌含量
在斑节虾上,遂溪乐民黄老板9月27日放斑节苗60万标粗,10月31日拿水虾样品到乐民海大技术服务站检测,检测后发现虾体弧菌严重超标。
遂开始使用清弧肽拌料,前四天清弧肽早晚拌喂一餐,每天两次,拌喂用量1%,后三天每天一餐,拌喂量1%。11月6日回访跟进,虾体肝脏无绿菌,一颗黄菌。
黄老板反馈调理后,虾子也变漂亮了,悬着的心也落下了。
△黄老板处弧菌检测结果,弧菌清除率95%以上
在白虾上,清弧肽效果同样优秀,防城港苏老板10月12日直放白虾苗45万,11月25日开始使用清弧肽+肝泰乐每日拌喂一餐,拌喂量1%,喂三天停四天,连续使用两个周期。
将过程中虾体弧菌变化进行统计,发现:使用第一个周期内,弧菌会有反弹现象,连续使用两个周期,虾体弧菌能稳定控制,效果显著。


在花虾上,清弧肽亦有同样的效果,南三岛陈老板,8月9号放花虾苗120万标粗,11月14日开始清弧肽每日拌喂一餐,连续一周,拌喂比例1.1%。
将过程中虾体弧菌变化进行统计,发现:清弧肽使用的第一天,料台虾子体内弧菌几乎清零;清弧肽使用的第五天,边上弱虾体内弧菌几乎清零,效果非常明显。

△陈老板处弧菌变化图,弧菌清除率90%,未反弹
效果点4:放苗就可使用,效果得到认可
滥用抗生素药物,对虾体组织器官健康会有一定影响,并诱发耐药性。而清弧肽依靠抗菌肽搭配营养物质,客户使用后认为特异性杀灭虾体肝胰脏和肠道的弧菌,对肝肠不产生毒副作用,能避免耐药性。
苗期使用清弧肽的客户已陆陆续续开始搬塘,像上文提到的黄老板,目前60万斑节苗已经搬塘,养殖78天,规格80头,共搬出6000斤,成活率80%,黄老板对清弧肽的增益效果特别认可。

△黄老板处搬塘,虾苗体色靓,活力好,成活率高
根据虾体内的弧菌含量及虾体健康程度,清弧肽的用量可以灵活调整。如果水体含量超标,也可以同时水体消毒,内服外消让弧菌无处可藏。
体内弧菌感染对虾器官——肝胰脏和肠道,因此体内弧菌超标时,为避免弧菌攻击肝脏,同时也要做保肝护肝管理。体内弧菌处理后,可以搭配虾多宝微软,恢复吃料。
具体使用方案如下:
虾体弧菌情况:
虾体弧菌总数<30000(cfu/ml)且绿菌<1000(cfu/ml),虾子健康。
使用方法:
清弧肽1包拌40斤料,每天1餐,连用3天,停3天,6天一周期。
虾体弧菌情况:
虾体弧菌总数>30000cfu/mL或绿菌>1000(cfu/ml),对虾肝脏发红或发黄,肠道断节;无偷死。
使用方法:
清弧肽1包拌20斤料,每天1餐,连用5天。弧菌得到控制后,转为预防使用方案。
水体消毒方案:
靓底+强力倍生源,消杀补菌,1亩各用1包;
保肝护肝方案:
肝泰乐+虾肝宝1天1餐,1包拌40斤料,使用3天;
健肠加料方案:
虾多宝微软,每天纯喂1餐,用3天,停3天,6天一周期。
从近三年华南对虾的养殖情况来看,不论何种模式、区域,弧菌病原已经日益猖獗,管控难上加难。为保障对虾顺利养殖,弧菌防控管理必须要升级强化。
回归养殖本身,一方面加强硬件改良,优化养殖操作;从水源质量、排污次数、稳水管理和天气管理等多方面入手,贯穿养殖全程,严防死守。
另一方面,在对虾内服板块,各类有益菌、中草药、生物活性肽以及抗生素等多种抗菌成分,清晰不同场景,逐级介入,减少耐药性,综合解决体内弧菌问题,这样才能最大程度防控弧菌,减少对养殖危害。
本文系海大农牧(微信号:haid002311)原创,未经授权,一律禁止转载!文章投稿、转载授权,欢迎发邮件到:haidnm@haid.com.cn
✪加海哥微信(haid-services03)
即可加入养殖交流群
及时获得养殖资讯✪


👇 咨询产品可点击"阅读原文"留言


